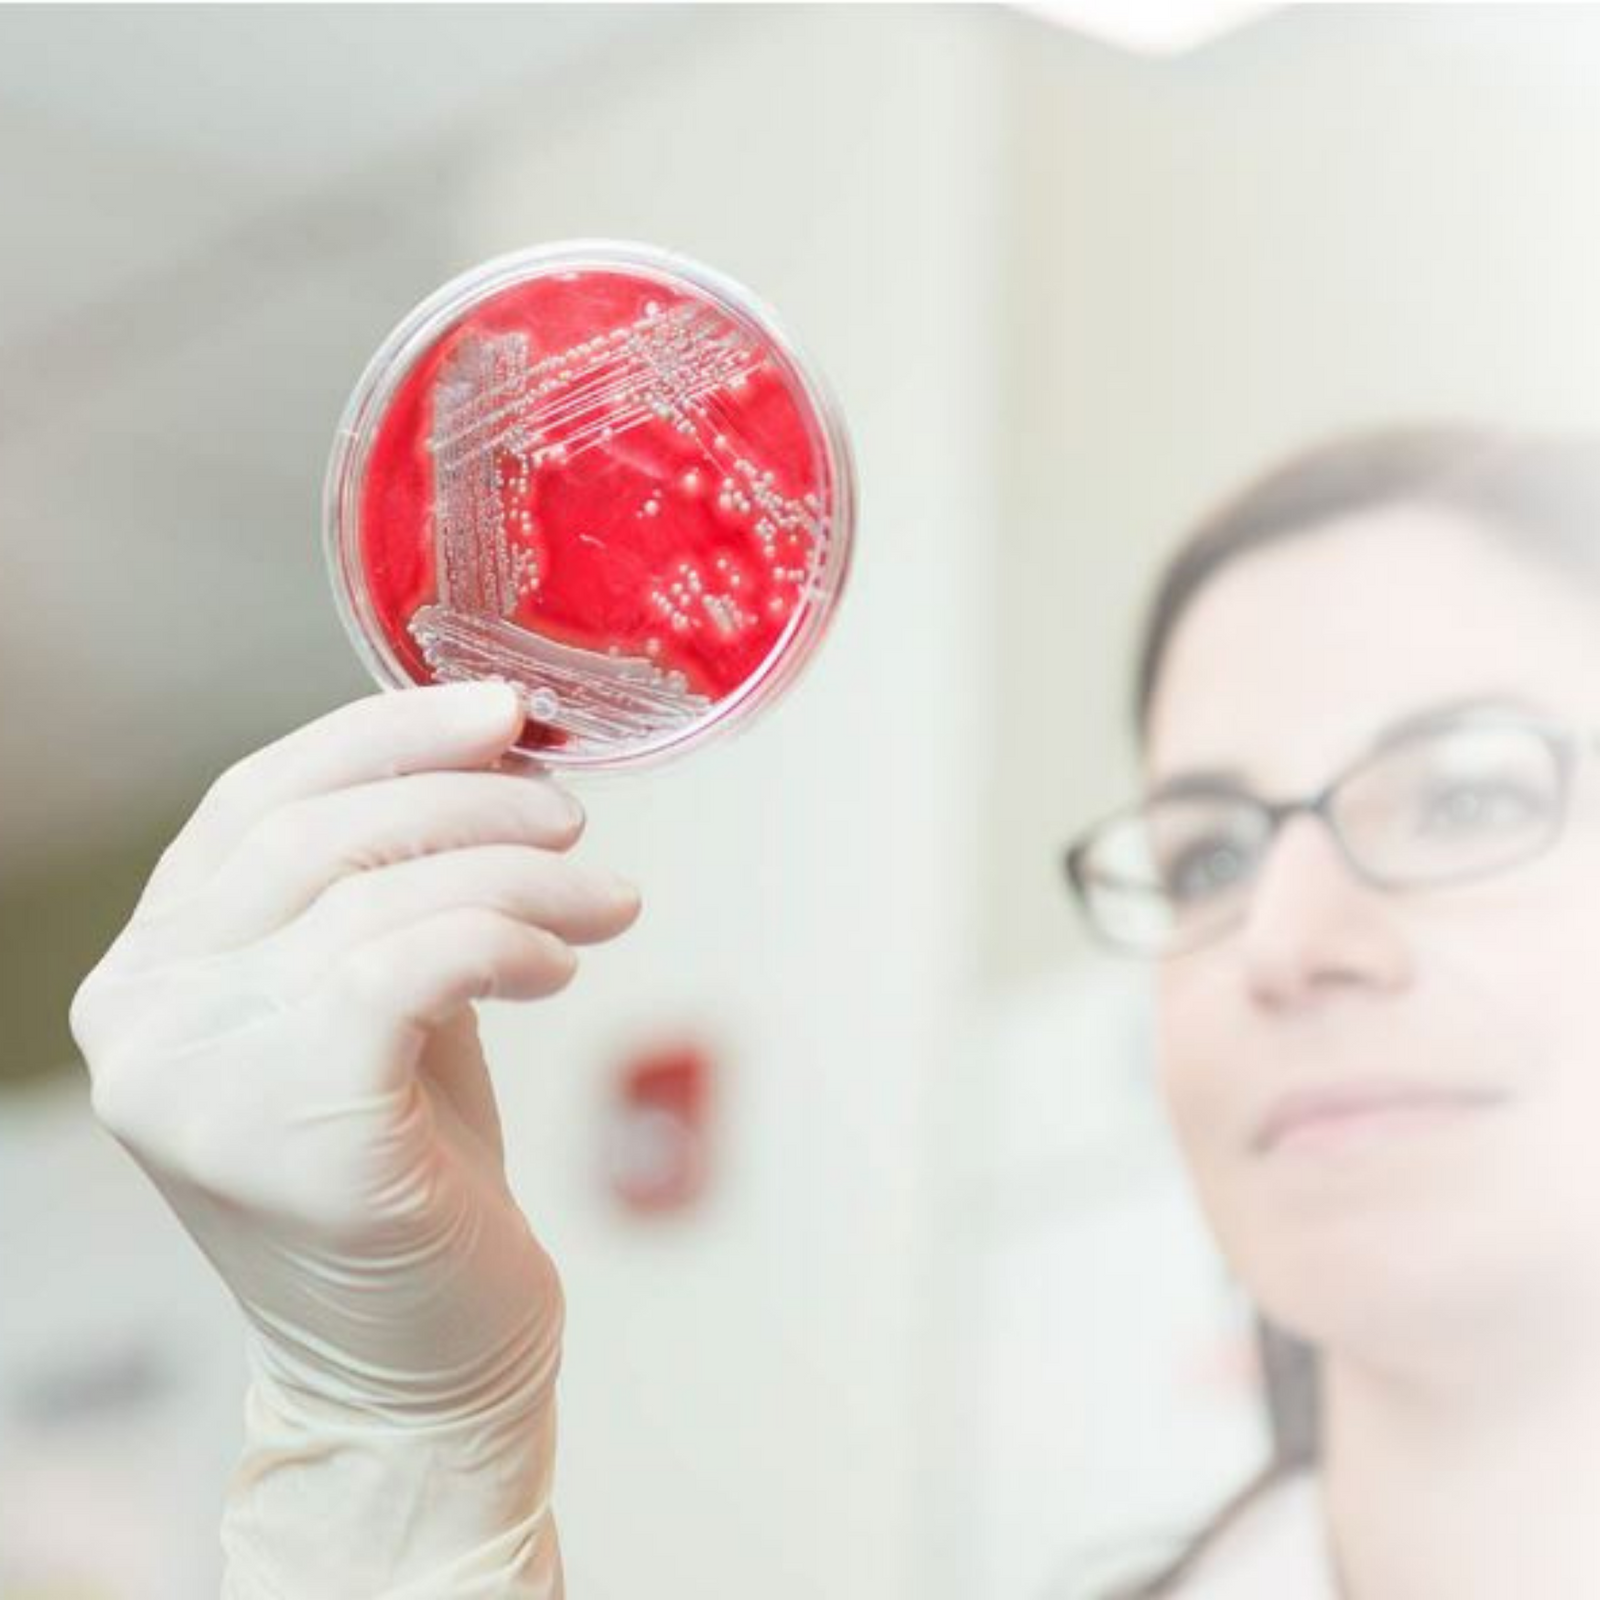

Orthobond is the product of over a decade of research, experimentation, collaboration, and persistence. Our original platform technology was first developed at Princeton University, with the intention of improving the performance of medical devices.
Initially, our interest was in creating device surfaces that would enhance osteoconductivity. However, in response to requests from our industry partners, we eventually pivoted to focus on developing antimicrobial nanosurfaces for medical devices.
Today, the issue of medical device contamination is becoming more widely recognized as a leading cause of device failure. In light of new data presented by recent studies and improved methods for detecting occult infection, researchers now estimate that the number of patients affected globally by medical device-related infections has been grossly underestimated.
Medical complications resulting from an infected medical device are serious, ranging from mild or severe pain, at best, to revision surgery, amputation, and/or death in more severe cases. Despite the implementation of improved air flow handling in ORs, guidance from the CDC on infection prevention, and the widespread adoption of double gloving and routine glove changes in orthopaedic surgery, the infection problem has remained and continues to grow.
With the emergence of antibiotic-resistant organisms and the rising rate of revision surgeries, the need for preventative measures is greater than ever.
Orthobond has developed a suite of proprietary, non-eluting, antimicrobial nanosurfaces for medical devices with applications in orthopedics, trauma, cardiovascular, plastic surgery, dental, oncology, and ancillary industries. Our technology can be successfully applied to the majority of biomaterials used in the medical device industry.
The literature suggests that there is a threshold level of bacterial contamination on a medical device, above which the chance for an infection is greatly increased. Orthobond’s antimicrobial nanosurface technology works by killing unwanted microbes on the surfaces of medical devices, thereby reducing the risk for microbial contamination.
Our technology has been shown in in vitro studies to dramatically reduce microbial contamination of medical-grade surfaces, successfully killing a wide range of microorganisms that are commonly found at the site of infected medical devices.
Orthobond is proud to announce that our treatment process is in its final stages of development toward commercialization. Orthobond’s platform technology enables our team to covalently or chemically bind molecules that can enhance the performance of implantable medical devices and surgical tools. Although we are currently focused on antimicrobials, Orthobond’s technology can be used to bind many other end groups. Orthobond customizes partners’ surfaces by matching substrates with specific end group molecules to elicit the desired biological response.
We look forward to continuing to work with companies that are committed to improving the performance and safety of their devices, for the benefit of patients, hospitals, payors, and industry. In the process, we anticipate that our partners will gain a significant competitive advantage.
Orthobond is powered by a dedicated team of researchers, scientists, and business leaders striving to improve patient care by developing breakthrough technologies for the medical device industry.
Meet the team that’s driving medical device innovation at the nanoscale.